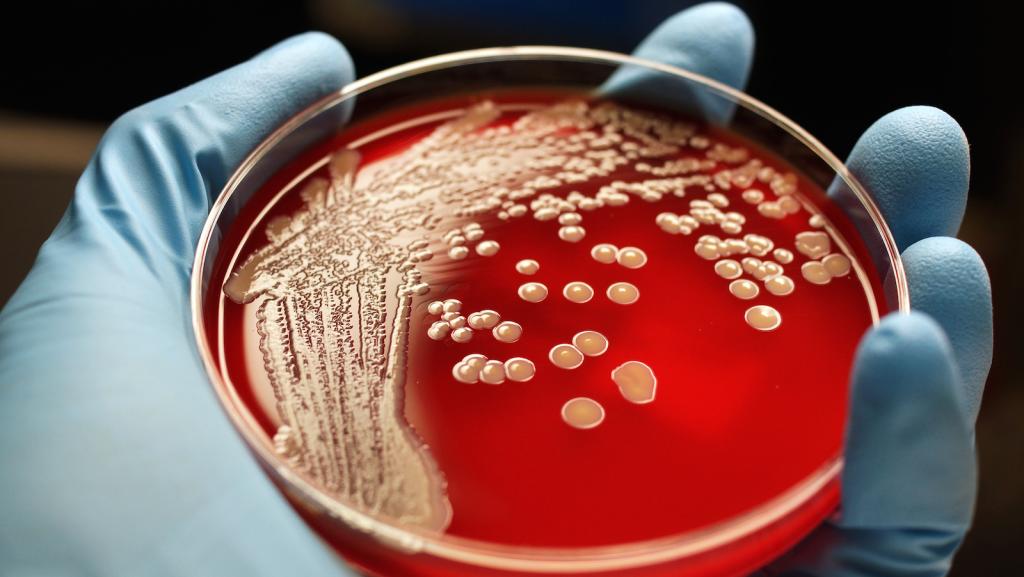

Articles by Miyo McGinn
Miyo McGinn, Grist editorial intern, fall 2019
All Articles
-
The U.N. report calls for better farming. Which 2020 candidates have a plan for that?
To take on the climate crisis, our next president must change the way we produce food and manage our land.
-
Uber and Lyft admit they’re terrible for traffic, finally
Ride-hailing services aren’t taking cars off the road, but a new transit experiment called Via might.
-
Lawsuit claims home spray-on fire retardant doesn’t work
Plus, it's toxic, California prosecutors say
-
The big climate significance of the planet’s microbiome
When it comes to figuring out the climate crisis, scientists say we need to think small.